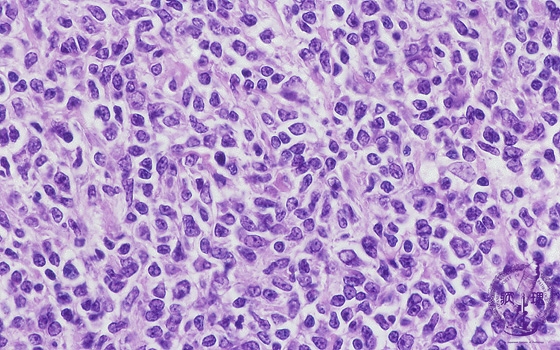
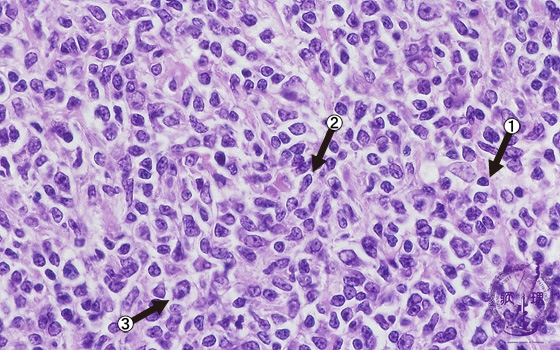

- 2.Lymph node
- ★(5)Follicular lymphoma
Microscopic image (H&E high power view): Nuclei of neoplastic lymphocytes are larger than those of mature lymphocytes (arrow No.1), but smaller than those of histiocytes. Some of the smaller tumor cells are called cleaved cells because their nuclei have irregular, notched borders (arrow No.2). Admixed centroblasts (arrow No.3) are larger tumor cells with prominent large nucleoli. The germinal center growth pattern is relatively monotonous in contrast to the heterologous appearance seen in non-neoplastic, reactive areas.
Click the image to see the enlarged image.